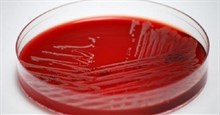
Sử dụng thuốc statin có thể làm giảm nguy cơ nhiễm trùng máu nguy hiểm

Ô nhiễm không khí, nguồn nước, thực phẩm nhiều hóa chất độc hại và thói quen sinh hoạt ăn uống của đa số người hiện nay chính là những nguyên nhân gây ra các bệnh mỡ máu gây nguy hiểm cho sức khỏe của hầu hết những người mắc phải.
Mỡ máu cao chủ yếu là do tăng cholesterol và triglycerid. Để xác định được lượng mỡ máu cao hơn bình thường người ta thường đánh giá bằng chỉ số xét nghiệm là định lượng nồng độ triglycerid toàn phần và nồng độ cholesterol.
Mỡ máu cao khiến cho người bệnh phải đối diện với nguy cơ bị mỡ đóng vào trong mạch máu, tạo thành một mảng xơ vữa, dễ dẫn đến tình trạng tắc mạch máu và làm vỡ mạch máu.
Đặc biệt, những người bị mỡ máu quá cao, tình trạng mạch máu bị bít, hẹp mạch máu nhiều hơn. Nếu xảy ra ở não thì có thể gây nên tai biến mạch máu não, nếu xảy ra ở ruột thì nguy cơ gây nên tắc mạch máu ruột dẫn đến hoại tử ruột.
Nếu xảy ra ở tim có thể gây ra nhồi máu cơ tim. Nếu xảy ra ở chi có thể gây tắc mạch máu chi...
Những hệ quả nguy hiểm do bệnh mỡ máu cao gây ra là người bệnh có nguy cơ mắc 7 bệnh nguy hiểm như bệnh viêm tụy, bệnh tiểu đường type 2, bệnh tim mạch, đột quỵ, bệnh gan, đau và tê bàn chân, sa sút trí tuệ...
Với bài thuốc dân gian mà nước Nga "quét sạch" mỡ máu cực kỳ hiệu quả suốt nhiều thập kỉ qua? Đây là cách thanh lọc máu, tống chất béo ra khỏi thành động mạch. Hãy cùng tham khảo qua công thức này nhé!

Chanh và tỏi là hai gia vị rất đỗi quen thuộc với căn bếp của hầu hết các gia đình, hai gia vị này được biết đến với rất nhiều công dụng có lợi cho sức khỏe như giảm béo, trị cảm đặc biệt là làm sạch thành mạch và giảm mỡ máu rất hiệu quả. Đây là phương pháp chữa bệnh dân gian của nước Nga và đã được nhiều người sử dụng và thành công ngoài sức mong đợi.
Nguyên liệu: 4 củ tỏi, 4 quả chanh, 3 lít nước sôi để nguội.
Cách làm: Tỏi bóc sạch vỏ. Chanh tiệt trùng bằng nước sôi cho sạch vi khuẩn, sau đó vớt ra cắt thành miếng nhỏ. Cho hai nguyên liệu trên với 3 lít nước sôi để nguội vào máy xay sinh tố xay nhuyễn, sau đó cho hỗn hợp vào một chiếc lọ thủy tinh, đậy nắp kín sau đó cho vào tủ lạnh để trong 3 ngày là bạn có thể mang ra sử dụng.
Cách sử dụng: Mỗi ngày dùng tối đa 50ml chia làm 3 lần, uống trước bữa ăn. Để phát huy công dụng của hỗn hợp này, bạn nên duy trì một liệu trình trong 40 ngày, mỗi năm chỉ làm 1 liệu trình.
Chú ý: Bài thuốc trên cũng có thể sử dụng để làm sạch các mạch máu, nhưng phải sử dụng với liều lượng thấp hơn, khoảng 1 - 2 muỗng canh/lần.
Bên cạnh đó, những loại cá cũng giúp bạn loại trừ máu độc bởi đây là một trong những cách để giảm cholesterol một cách tự nhiên. Các loại cá như cá hồi và cá ngừ, rất giàu omega -3 đây là loại thực phẩm giúp làm giảm cholesterol.
Hướng dẫn AI
Học IT

Hàm Excel